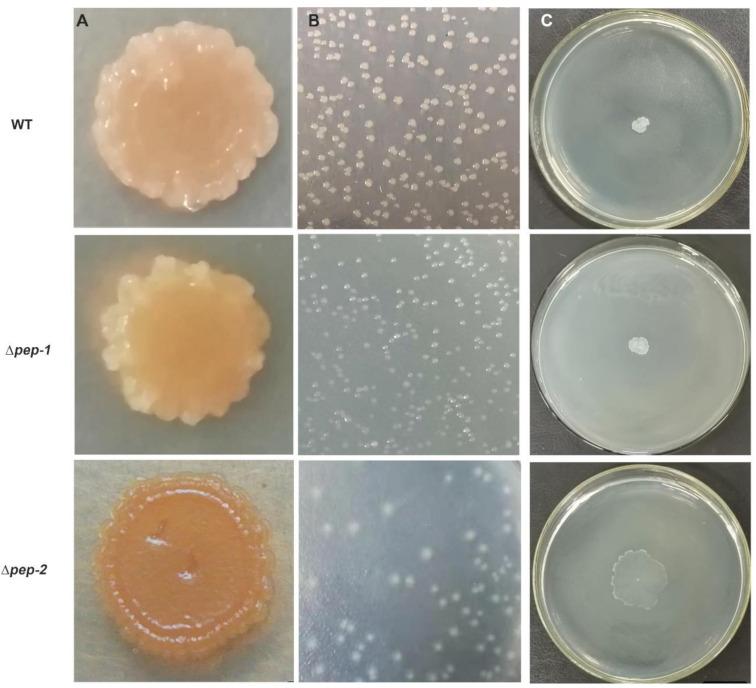

WLY78的EPS生物合成基因簇在有氧条件下对生物膜形成和固氮的影响
Effects of an EPS Biosynthesis Gene Cluster of WLY78 on Biofilm Formation and Nitrogen Fixation under Aerobic Conditions.
作者信息
He Xiaojuan, Li Qin, Wang Nan, Chen Sanfeng
机构信息
State Key Laboratory of Agrobiotechnology and College of Biological Sciences, China Agricultural University, Beijing 100193, China.
Biotechnology Research Institute, Chinese Academy of Agricultural Sciences, Beijing 100081, China.
出版信息
Microorganisms. 2021 Jan 30;9(2):289. doi: 10.3390/microorganisms9020289.
Exopolysaccharides (EPS) are of high significance in bacterial biofilm formation. However, the effects of EPS cluster(s) on biofilm formation in species are little known. In this study, we have shown that WLY78, a N-fixing bacterium, can form biofilm. EPS is the major component of the extracellular matrix. The genome of WLY78 contains two putative gene clusters (designated cluster and cluster). The cluster is composed of 12 putative genes () co-located in a 13 kb region. The cluster contains 17 putative genes () organized as an operon in a 20 kb region. Mutation analysis reveals that the -2 cluster is involved in EPS biosynthesis and biofilm formation. Disruption of the -2 cluster also leads to the enhancement of motility and change of the colony morphology. In contrast, disruption of the cluster does not affect EPS synthesis or biofilm formation. More importantly, the biofilm allowed WLY78 to fix nitrogen in aerobic conditions, suggesting that biofilm may provide a microaerobic environment for nitrogenase synthesis and activity.
胞外多糖(EPS)在细菌生物膜形成中具有重要意义。然而,EPS簇对物种生物膜形成的影响却鲜为人知。在本研究中,我们发现固氮细菌WLY78能够形成生物膜。EPS是细胞外基质的主要成分。WLY78的基因组包含两个假定的基因簇(分别命名为簇和簇)。簇由12个假定基因()组成,共定位在一个13 kb的区域。簇包含17个假定基因(),在一个20 kb的区域内组织成一个操纵子。突变分析表明,-2簇参与EPS生物合成和生物膜形成。-2簇的破坏还导致运动性增强和菌落形态改变。相比之下,簇的破坏不影响EPS合成或生物膜形成。更重要的是,生物膜使WLY78能够在有氧条件下固氮,这表明生物膜可能为固氮酶的合成和活性提供一个微需氧环境。